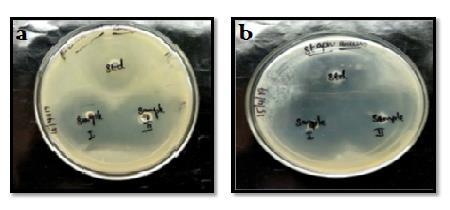

ISSN 2348-313X (Print)
International Journal of Life Sciences Research ISSN 2348-3148 (online)
Vol. 8, Issue 4, pp: (70-78), Month: October - December 2020, Available at: www.researchpublish.com

ISSN 2348-313X (Print)
International Journal of Life Sciences Research ISSN 2348-3148 (online)
Vol. 8, Issue 4, pp: (70-78), Month: October - December 2020, Available at: www.researchpublish.com
1Assistant Professor, Department of Biochemistry, St.Joseph’s College of Arts and Science, Cuddalore.
2 Associate Professor, Department of Biochemistry, Thiruvalluvar Arts and Science College, Kurinjipadi.
3,4 Assistant Professor, Department of Biochemistry, St.Joseph’s College of Arts and Science, Cuddalore
Abstract: The present study of this work is to prepare a novel wound dressing composites are enriched with medicinal values which prevents the microbial contaminations and cell damage to the wounded surface. So that the films consist of antioxidant and antimicrobial properties are an appreciable one for the composite film. In this studies, gelatin is a proteinous substance isolated from the chicken feet along with sodium alginate, the composite films are prepared and these films are enriched with ethanolic extract of black turmeric (Curcuma Caesia Roxb ). The composite films are prepared and characterised for FTIR, SEM, mechanical strength, water absorption studies and also evaluate the invitro studies such as antioxidant and antimicrobial activities. As the result, shows that the G-ALG-CC increased water absorption capacity and better mechanical properties of film in contrast to GALG. The SEM and FTIR results exhibit the natural features of the composite film. The G-ALG-CC composite film possess significantly increased levels of antioxidant and antimicrobial activity. The Scanning Electron Microscope images of G-ALG-CC reveals the smooth surface of the film which is necessary requirement of the biomaterial.
Keywords: Gelatin, alginate, black turmeric, curcuma caseia, composite film.
Many kinds of biomaterials are used to treat various diseases especially wound healing. Several components are exist as naturally in the skin and also actively participated in the wound healing process. Due to their natural biological features of biodegradability and biocompatibility of these components are favourably approached for various therapeutic purposes [1]. There is very much need to develop a novel biodegradable material, which is widely used in the field of skin tissue engineering and wound healing material due to the their high demand for skin repair and skin replacement therapies. An ideal film should exhibit certain behaviour such as diminished storage requirement, increased shelf life, biodegradability and biocompatibility [2].
Gelatin is an excellent biopolymer which is obtained from the poultry byproducts such as bone, feet, cartilage and skin [3]. It is an edible proteinous product derived from the denatured collagen [4]. The native conformation of the collagen is deformed due to heating and then regaining their normal state while cooling process. The amino acid composition of gelatin is more or less similar to collagen with some modification occurs due to their extraction process [5]. It is rich in proline, hydroxyproline, alanine and glycine, but varying in distinct ratios and combinations [6]. The promising physical features of Gelatins are translucent, colorless, tasteless, odorless, high mechanical strength, low melting point, elasticity, and increased shelf- life [7]. The peculiar features of gelatin have an ability to form thermoreversible gels and highly water soluble that meets the body temperature [8]. The nature of the gelatin are biodegradable, biocompatible and nontoxic which is suitable for the physiological conditions [9]. Gelatins are categorized into two types based on their
ISSN 2348-313X (Print)
International Journal of Life Sciences Research ISSN 2348-3148 (online)
Vol. 8, Issue 4, pp: (70-78), Month: October - December 2020, Available at: www.researchpublish.com
chemical treatments which is used during the extraction process. The type A gelatin shows the isoionic point ranges between 7 to 9 which is derived from acid treatment while the type B is produced by alkali treated gelatin which attains the isoionic point ranges between 4.8 to 5.6 [10].
Gelatin is recognized as an exudates, because it minimizes the fluid discharge and also progressing the wound healing process [11].It is mostly used as a functional foods and also it possess medicinal values. Its having film-forming capacity, abundance in nature and maintaining the gaseous barrier effects, but the gelatin films alone having certain demerits such as high fragility and low mechanical properties. Therefore, to improve the characteristic features of gelatin films by adding varieties of polymers such as polysaccharides and lipids [12]. It performs an indispensable roles in various fields such as pharmaceuticals, cosmetics photography and food processing industries. In food industries, it is used to enhance the stability and consistency of processed food stuffs. In the medical and pharmaceutical fields, it can be manufactured both hard and soft capsules, wound dressing materials and adsorbent pads.[13]
Alginate is the naturally occurring anionic polysaccharide which is obtained from the sea weed and brown algae. It is widely used in the fields of medicine and also food Industries. It consists of two structural moieties of α- 1,4 L-guluronic acid (G) and β-D-mannuronic acid (M). It is also a kind of biomaterial that possess various biomedical applications due to their suitable properties such as biocompatibility and biodegradability. It has an excellent film forming ability with desirable mechanical strength. [14],][15]
Medicinal plants are rich in bioactive constituents that has been utilized in various forms of biomedical applications especially wound healing. Though the plants possess significant medicinal properties, it becomes necessary to explore in detail before the drug development (Ncube NS et al). Many evidences have proven that the Indian traditional systems comprises too many plants that exhibits desirable medicinal values which are safe, non-toxic and their effectives causing very minimal adverse effects [16].
Black turmeric (Curcuma caesia Roxb) is famously called as Kali haldi comes under the family Zingiberaceae. Nearly 200 species are found in all over the world. It is rare variety but the structural features and aroma are similar to turmeric [17] The dried black turmeric rhizomes are highly commercial and also it possesses significant medicinal properties. The major bioactive constituents present in the turmeric is Curcumin, which is extracted from the black turmeric. It can be used to treat several diseases such as hemorrhoids, leprosy, asthma, cancer, epilepsy, fever, wound, vomiting, menstrual disorder,muscle relaxant activity, anthelmintic, aphrodisiac and inflammation[18]. Naturally, curcumin having antibacterial, antioxidant, antiproliferative and antiinflammatory activities. The antioxidant and antiinfalmmatory activities are exhibits to prevent the cell damage [19].
The aim of the present study is to prepare a novel composite film containing gelatin and alginate. In addition to that ethanolic extracts of black turmeric is enriched with gelatin and alginate films for wound dressing material. Afterwards, the antioxidant and antimicrobial properties of this wound dressing composites were evaluated by invitro studies.
Chicken feet and Curcuma caesia roxb rhizomes were procured from local market, Cuddalore. Alginate, DPPH and then each and every chemicals used in this study were of analytical grade.
The Curcuma caesia (CC) were washed thoroughly with tap water to remove the sand and dust particles. The rhizomes were minced and allowed to dry at room temperature for 72 hours. The dried rhizome were powdered into fine particles in the range of 100-200 µm. 8 grams of CC powder was extracted with 100ml of ethanol. The extraction process was done by the soxhlet apparatus. The extracted solution was filtered and then used for furthermore analysis.
2 grams of sodium Alginate was weighed and dissolved in 100ml distilled water. The solution was placed on the magnetic stir for 20 minutes and allow to maintain the temperature between 70-80 0C to make sure that the sodium alginate solution should be completely homogenised.
ISSN 2348-313X (Print)
International Journal of Life Sciences Research ISSN 2348-3148 (online)
Vol. 8, Issue 4, pp: (70-78), Month: October - December 2020, Available at: www.researchpublish.com
Chicken feet were obtained from slaughter house and washed thoroughly in running water then remove the nails and skin from the bone and washed thoroughly with distilled water for 3-4 times. Then the bone was immersed in a boiling water and allow to maintain the temperature at 50°C for 45 minutes to remove the scales. Furthermore, washed the bones and minced into small pieces and then soaked in 0.1% NaOH solution for 40 minutes, then washed with tap water (repeated up to four times), then soaked in 0.1% sulfuric acid solution for 40 minutes, washed with tap water (repeated up to three times).
Furthermore, the descaled bones were soaked in 0.4% citric acid solution for 40 minutes, washed with tap water (repeated up to three times). Afterwards, the feet was soaked in distilled water and placed into boiling water bath and allow to maintain the temperature at 55°C for 90 minutes. Finally, the gelatin was extracted from the chicken feet. The extracted gelatin was filtered by using filter paper. The filtered gelatin solution was allowed to dry and maintain the temperature at 70°C for 10 hours and stored for further analysis [20].
The nature of the gelatin film was dried it becomes fragile in nature. To avert this fragile nature of the film, ethylene glycol (EG) was included to improve the plasticity of the film. The amount of gelatin solution was constant and the various amount of EG was added and the details were depicted in table 1a. Hence, the homogenous solutions were poured in the polythene tray having the size of 10×10 cm and dried at 370C. The films were dried and kept safely in polythene bags for future use.
The stoichiometric ratio of the G film provides better tensile strength properties and these film was used for the preparation of G-ALG composite films. The amount of gelatin solution and EG was constant, but the amount of alginate solution was different and the details are given in table 1b. Hence, the homogenous solutions were poured into the polythene tray having size of 10×10 cm and dried at room temperature. The films were dried and kept safely in polythene bags for future use.
The stoichiometric ratio of the G-ALG film provides better tensile properties and these films was utilized for the preparation of composite film G-ALG-CC. The amounts of G-ALG solution and EG constant and the details were given in theTable 1c, but the various amount of CC solution was added (Table1c) and these solutions were poured into the polythene trays having size of 10×10 cm, and dried at room temperature.
The prepared samples were punched out with die by using three dumbbell-shaped specimens of 4 mm wide and 10 mm length. Instron tensile testing machine model 4501 which was used to determine the tensile strength (MPa) and elongation at break (%) of the composite films.
The Water absorption studies were determined by the procedure of Rao et al The water absorption capacity of the prepared samples were estimated by using small pieces of known weight of the sample was immersed with the distilled water at 370C . The distend weight of the sample was estimated by an initial blotting of the samples with an aid of filter paper proceeded by exactly weighing of the sample. The weights of the distended sample pieces were observed every 1 h, 2 h, 3 h and after 24 h. The percentage of swelling pieces of each samples at prescribed time was measured by the formula
Es = (Ws - Wo / Wo) X 100
Where, Ws is the weight of the sample (moist) at given time, Wo is the initial weight of the sample, Es is the percent of swelling at a given time.
ISSN 2348-313X (Print)
International Journal of Life Sciences Research ISSN 2348-3148 (online)
Vol. 8, Issue 4, pp: (70-78), Month: October - December 2020, Available at: www.researchpublish.com
SEM consists of Fissions sputter coater that coats the sample with gold ions with the help of an ion coater. It works under the pressure of 0.1 torr. The current source applied for the SEM as 20 mA and the coating time was70 s . Surface morphology of the sample was observed by SEM for applying the voltage of 15 kV.
The samples prepared for the spectral studies were analysed by using Nicolet impact 400 FTIR spectroscopy by formulate a pellet consist of 500 mg KBr and 2–6 mg of sample.
The DPPH assay was used to determine the free radical-scavenging capacity of G-ALG and G-ALG-CC films were estimated, the procedure for this assay was explained by Bersuder et al. Both the films were chopped into 2x2 cm and then put the samples into 1 ml of distilled water. Moreover, these films were dissolved and then add 99.5% of ethanol and 0.02% of DPPH solution. As the resultant solution were placed in the dark condition for 60 min at 370C. After completion of the incubation period, the homogenised solution was centrifuged at 5,000rpm for 5 min and then absorbance was read at 517 nm using a UV–vis spectrophotometer. The control was performed in the same way, apart from that distilled water was served as control instead of composite films. The DPPH radical scavenging activity was measured by using the formula as follows: where Ac and Ah are the absorbance of control and sample, respectively. A lower absorbance of the reaction mixture indicated higher DPPH radical-scavenging activity. The test was carried out in triplicate.[21]
DPPH free radical-scavenging activity (%) = (Ac−Ah Ac) x 100.
The antibacterial activity was determined by well diffusion methods (Holder and Boyce, 1994). About 25ml of molten Muller Hinton agar (MHA) were poured into a sterile Petri plate (Himedia, Mumbai, India), The plates were allowed to solidify, after which 18 hours grown (OD adjusted to 0.6) 100 µl of above said strains culture were transferred onto plate and made culture lawn by using sterile cotton swab. After few minutes setting of the strains, a sterile Cork borer was used to make 6mm well on the agar. The test samples were loaded into wells with various concentrations such as 50µg, 100µg, 150µg, and 200µg/well. The standard was used as a positive control. The plates were incubated at 37˚C in a bacteriological incubator for 24-48 hrs. The antibacterial activity was determined by measuring the diameter of the zone around the well using antibiotic zone scale (Himedia, Mumbai, India).
The mechanical properties of the composite films of G, G-ALG and G-ALG-CC as shown in the table 1a,b and c respectively. The table 1a exhibits the various amounts of Ethylene glycol is a plasticizer used in the G film. Thus the 2 ml of Ethylene glycol was added to the gelatin film i.e in the table 1a sample No.2 which shows the best mechanical properties and decreased elongation at break. The mechanical properties of G-ALG and G-ALG-CC film has shown in the table 1b& c respectively. The sample No 3 in table 1b & sample no 1 in the table 1c which a gave a best mechanical strength and their elongation at break were decreased.
Table I a: Mechanical Properties of Gelatin Film (G)
Sample No Gelatin(ml) EG (ml) Elongation at break (%) Tensile strength(MPa)
1 40 1 11.29±2.35 4.09±0.37 2 40 2 10.25±2.5 5.20±0.43 3 40 3 13.28±1.34 2.29±0.14 4 40 4 11.10±1.95 1.95±0.11
ISSN 2348-313X (Print)
International Journal of Life Sciences Research ISSN 2348-3148 (online) Vol. 8, Issue 4, pp: (70-78), Month: October - December 2020, Available at: www.researchpublish.com
Table I b: Mechanical Properties of G-ALG Film
Sample No Gelatin (ml) Alginate (ml) EG (ml)
Elongation at break (%)
Tensile strength (MPa)
1 40 10 2 20.7±2.8 6.43±0.46 2 40 20 2 31.4±2.1 7.49±1.68 3 40 30 2 25.9±2.4 8.29±0.48 4 40 40 2 32.03±2.39 6.49±1.12
Table I c: Mechanical Properties of G-ALG-CC Film
Sample No Gelatin (ml) Alginate (ml) EG (ml) CC extract (ml)
Elongation at break (%)
Tensile strength (MPa)
1 40 30 2 1 21.53±3.43 16.22±0.8 2 40 30 2 2 22.67±2.94 9.06±2.5 3 40 30 2 4 26.89±3.98 9.4±1.29 4 40 30 2 6 24.21±3.16 10.48±1.8
The water absorption capacity of the G-ALG and G-ALG-CC films has shown in the figure 1. The G-ALG film exhibits increased water absorption capacity reaches the maximum at 190% in contrast to G-ALG-CC composite film.
GL-ALG GL-ALG-CC
Scanning
Figure 1: Water absorption capacity of GL-ALG and GL-AG-CC
The SEM images of G-ALG and G-ALG-CC has shown in the figure 2 a & 2b respectively. The G-ALG film shows the porous and smooth surface and G-ALG-CC film exhibits very smooth as compared to the G-ALG film

2:
of
of G-ALG-CC
ISSN 2348-313X (Print)
International Journal of Life Sciences Research ISSN 2348-3148 (online) Vol. 8, Issue 4, pp: (70-78), Month: October - December 2020, Available at: www.researchpublish.com
The FTIR spectrum of G-ALG and G-ALG-CC has shown in the figure 3a and 3b. The FTIR shows the presence of amide I, II, III peaks at 1628.99cm-1, 1544.07 cm-1 and 1242.45 cm-1 in G-ALG composite film. The peak range at 1081.13 cm-1 shows the presence of protein. The peaks at 2926.22 cm-1 and 1081.13 cm-1 show the alkyl chain moiety of alginate and glucuronic acid which exhibits the presence of alginate in this composite film. After addition of Curcuma Caesia rhizome extract (G-ALG-CC) the amide I and amide II were reflected at 1636.64 cm-1 and 1550.26 cm-1

Figure 3: a) FTIR peaks of G-ALG & b) G-ALG-CC
In Vitro Antioxident Activity
The composite films of G-ALG and G-ALG-CC were determined by DPPH free radical scavenging activity has shown in the table 2. From the investigation of free radical scavenging analysis, G-ALG-CC shows an excellent scavenging properties. The G-ALG-CC composite film which exhibits increased antioxidant activity that depends on the concentration as compared with G-ALG films
Table II: DPPH assay of G-ALG & G-ALG-CC
G-ALG 75.7±0.27
G-ALG-CC 81.3±0.42 (100 µg/ml) G-ALG-CC 88.5±0.56(200µg/ml)
The G-ALG and G-ALG-CC films were effectively killed the bacterial pathogens examined at different level of concentrations has shown in the figure 4. The concentration of G-ALG is 50µg/well was showed microbial activity ranged from 9mm to 12 mm zone of inhibition as compared to G-ALG-CC films exhibit an effective activity ranged from 200µg/well showed zone of inhibition ranged from 10mm to 16mm (Figure 4).
The G-ALG and G-ALG-CC films were effectively killed the bacterial pathogens examined at different level of concentrations has shown in the figure 4. The concentration of G-ALG is 50µg/well was showed microbial activity ranged from 9mm to 12 mm zone of inhibition as compared to G-ALG-CC films exhibit an effective activity ranged from 200µg/well showed zone of inhibition ranged from 10mm to 16mm
ISSN 2348-313X (Print)
International Journal of Life Sciences Research ISSN 2348-3148 (online)
Vol. 8, Issue 4, pp: (70-78), Month: October - December 2020, Available at: www.researchpublish.com
Naturally, gelatin having film formimg ability which provides increased mechanical properties, so that the film was easily brittle. To improve the mechanical properties of the gelatin film by adding sodium alginate. The biopolymers of Gelatin and alginate are an ability to form a film, but the mechanical properties of the film which was not appreciably used in the biomedical fields. So that the plasticizer was used to ameliorate the mechanical properties of the films. In the present study reveals that the Ethylene glycol was used as plactizier which was required to the film. Among the different compositions of gelatin films were studied in sample No.2 in the table 1 exhibits better tensile strength and elongation properties. To increasing the volume of ethylene glycol up to 2ml obviously, the tensile strength also raised and then decreased. When the tensile strength was decreased due to the increased amount of EG molecules may be imbibed with a hydroxyl group containing amino acid in protein backbone of gelatin. This composition of sample No.2 (table 1) was used to prepare G-ALG composite. Among the various compositions of G-ALG composite film prepared, sample No.3 in the table 2 gave better mechanical properties and this stoichiometric composition was used to prepare G-ALG-CC films. To increasing the concentration of curcuma cassia the tensile strength of the composite films raised in the beginning and then reduced. Moreover, the elongation at break is decreased. The stoichiometric ratio of 40 ml gelatin, 30 ml alginate, and 1ml of CC solution shows better tensile strength when compared to other films. Hence sample No.1 (table 3) was used for further characteristics studies such as FTIR, SEM, Water absorption, and invitro antioxidant and antimicrobial studies.
The water absorption capacity is an essential feature of the composite films because it has sucked the wound discharges and make the injured area should be dry and also increases the wound healing process. The water absorbing ability of GALG film shows greater water absorption capacity when increasing the time periods. After 24hrs, it reaches maximum absorption at 190%. Moreover, the G-ALG-CC film has shown decreased water absorption capacity when compared to GALG film. The decreased water absorption was due to the amino and carboxyl groups of gelatin were cross linked to the aldehyde and amine groups of CC which was masked the hydrophilic groups present on its backbone. Because of this fact, the G-ALG-CC film possess lesser extent of water absorption.
Scanning electron microscope images reveals the morphological features of the composite films. In this studies, the scanning electron microscope images were observed for G-ALG and G-ALG-CC. Both the films has shown porous and smooth surface. However, the surface of the G-ALG-CC film was much better smoother compared to the G-ALG film. The smooth and the porous surface of these films were encouraged to absorb the wound bleedings and gaseous exchange also takes place in the injured site.
The spectral analysis of G-ALG and G-ALG-CC has shown in the figure 14 and 15. The FTIR exhibits the presence of amide I, II, III peaks at 1628.99cm-1, 1544.07 cm-1 and 1242.45 cm-1 in gelatin- alginate (G-ALG) composite film. The peak range at 1081.13 cm-1 shows the presence of stretching of protein. Normally, gelatin from chicken feet exhibits peaks at 1658.74 cm-1 to the amide I, 1552.44 cm-1 to the amide II and 1236.36 cm-1 to the amide III (Almeida et al). The peaks at 2926.22 cm-1 and 1081.13 cm-1 show the alkyl chain moiety of alginate and glucuronic acid which exhibits the presence of alginate in this composite film. After addition of Curcuma caesia rhizome extract (G-ALG-CC) the amide I and amide II were reflected at 1636.64 cm-1 and 1550.26 cm-1. A peak at 1335.5 cm-1 indicates the presence of alkene (CH) groups of curcuma caesia. A boarding of OH peak from 3000-3500 cm-1 indicating the hydrogen bonding between gelatin, Alginate and Curcuma caesia.
The antioxidants are agents that suppress the free radicals generation. DPPH assay has been used to determine the ability of the composite films act as a role of free radical scavenging activity. The results of DPPH assay are shown in the table2. The antioxidant activity of G-ALG and G-ALG-CC composite film were monitored by DPPH radical scavenging activity. The DPPH assay is based on the ability of antioxidant agents to provide a hydrogen atom to stabilize free radicals and
ISSN 2348-313X (Print)
International Journal of Life Sciences Research ISSN 2348-3148 (online) Vol. 8, Issue 4, pp: (70-78), Month: October - December 2020, Available at: www.researchpublish.com
convert into more stable products. The radical scavenging activity of G-ALG and G-ALG-CC composite film was 75.7%, 81.3% and 88.5% respectively. The G-ALG-CC composite film which exhibits increased antioxidant activity as compared with G-ALG-CC films. Furthermore, the antioxidant activity was found to be concentration dependent with increased with the increase of concentration of Curcuma Caesia (CC). G-ALG-CC film having significanlty increased free radical scavenging activity.
The composite films developed for this study has shown the maximum zone of inhibiton against the two bacterial strains. When the increased concentration of the composite film is directly proportional to the increased zone of inhibition has shown in the figure 4. The concentration of G-ALG is 50µg/well was showed microbial activity ranged from 9mm to 12 mm zone of inhibition as compared to G-ALG-CC films exhibit an effective activity ranged from 200µg/well showed zone of inhibition ranged from 10mm to 16mm . Among the organisms tested, the G-ALG-CC are active against bacterial pathogens
In this present work, the optimal levels of Gelatin, alginate and ethanolic extracts of Curcuma Caesia composite films were prepared at different proportions Thus the composite films exhibits the better tensile properties The structural features of the composite film was characterised by FTIR.. The SEM studies of the composite films has shown the smooth surface morphology. Apart from that the invitro antioxidant and antimicrobial activities were found to increase significantly to the wound healing process. Moreover the gelatin films were prevent the inflammation and oxidative damage. Thus the film may be matrix bearer for antioxidant and antimicrobial bioconstutients that has to encourage the wound healing activity.
[1] Muhammad Taufik, Suharjono Triatmojo, Yuny Erwanto, and Umar Santoso, “Effect of broiler age and extraction temperature on characteristic chicken feet skin gelatin, ” The 5th International Seminar on Tropical Animal Production Community Empowerment and Tropical Animal Industry Yogyakarta, Indonesia 19-22, October. 2010.
[2] V. Ramnath ,S. Sekar , S. Sankar, C. Sankaranarayanan and T. P. Sastry, “ Preparation and evaluation of biocomposites as wound dressing material,” J Mater Sci: Mater Med 23:3083–3095, 2012.
[3] Norizah Mhd Sarbon , Farah Badii, Nazlin and K. Howell,”Preparation and characterisation of chicken skin gelatin as an alternative to mammalian gelatin,” Food Hydrocolloids Volume 30, Issue 1, pp. 143-151, January. 2013.
[4] Songchotikunpan, P, Tattiyakul, J. and Supaphol, P, “Extraction and electrospinning of gelatin from fish skin,”International Journal of Biological Macromolecules 42(3): 247-55, 2008.
[5] Marina Ramos, Arantzazu Valdés, Ana Beltrán and María Carmen Garrigós,“ Review Gelatin-Based Films and Coatings for Food Packaging Applications,” Coatings: 6, 41,2016.
[6] Nor M M, Nazmi N N M and Sarbon N M, “ Effect of different hydrophilic plasticizer concentrations on functional properties of chicken skin gelatin films,” International Food Research Journal 24 5 1910-1918. 2017.
[7] Karim AA and Bhat R, “Fish gelatin: properties, challenges, and prospects as an alternative to mammalian gelatins,”Food Hydrosol; 23:563-576. 2009.
[8] Jian-Hua Li Jing Miao, Jiu-Lin Wu and Shan-Fei Chen, “Preparation and characterization of active gelatin-based films incorporated with natural antioxidants,” Food Hydrocolloids 37:166–173. June 2014.
[9] A Kamari A Kamari, A L A Halim, S N M Yusoff and S Ishak, “Gelatin film incorporated with banana leaf essential oil for food preservation ,” J. Phys.: Conf. Ser. 1097 012047.2018.
[10] Ruri Widyasari and Saroat Rawdkuen “ Extraction and characterization of gelatin from chicken feet by acid and ultrasound assisted extraction,” Food and Applied Bioscience Journal, 2 (1): 83-95.2014.
[11] SabrineSellimi, Khaled BenLassoued, Sabrine Beltaief, Nabil Souissi, Leticia Mora, Fidel Toldra, Abdelfatteh Elfeki and MoncefNasri, “Wound healing activity of cuttlefish gelatin gels and films enriched by henna (Lawsonia inermis) extract,” Colloids and Surfaces A: Physicochemical and Engineering Aspects, Volume 512, 1, Pages 71-79, January. 2017.
ISSN 2348-313X (Print) International Journal of Life Sciences Research ISSN 2348-3148 (online) Vol. 8, Issue 4, pp: (70-78), Month: October - December 2020, Available at: www.researchpublish.com
[12] Gómez-Guillén M C, Giménez B, López-Caballero M A and Montero M P, “Functional and bioactive properties of collagen and gelatin from alternative sources: A review,’’ Food Hydrocolloids 25 8 1813-1827.
[13] Wu, J., Chen, S., Ge, S., Miao, J., Li, J. and Zhang, Q,“Preparation, properties and antioxidant activity of an active film from silver carp (Hypophthalmichthys molitrix) skin gelatin incorporated with green tea extract” Pharmacology of Curcuma. Planta Med 57: 1-7.1991.
[14] Jessica Miranda Rosa, Letícia Bicudo Bonato, Carolina Bragine Mancuso,, Laira Martinelli, Mônica Hitomi Okura,Geoffroy Roger Pointer Malpass and Ana Claudia Granato Cienc,“ Antimicrobial wound dressing films containing essential oils and oleoresins of pepper encapsulated in sodium alginate films”, Rural vol.48 no.3 Santa Maria 2018 Epub Mar 22, 2018.
[15] Phase Dian Pribadi Perkasa, Erizal, Tri Purwanti , and Alva Edy Tontowi, “ Characterization of SemiInterpenetrated Network Alginate/Gelatin Wound Dressing Crosslinked at Sol Phase”, Indones J. Chem, 18 (2), 367 – 375,2018.
[16] Brigita Lapornik and Mirko Prošek Alenka Golc Wondra, “ Comparison of extracts prepared from plant by-products using different solvents and extraction time”, Journal of Food Engineering 71(2):214-222, Nov.2005.
[17] Chungkham Helini Devi, Renuka Nameirakpam and Premila Chanu,“In Vitro regeneration studies of Black Turmeric (Curcuma Caesia Roxb),” International Journal of Current Research Vol.8, Issuse, 04, pp.29203-29206, April.2016.
[18] Sonjit Das, ProdyutMondal and Md. Kamaruz Zaman, “Curcuma caesia roxb. And it’s medicinal uses: a review”, International Journal of Research in Pharmacy and Chemistry. 3(2), pp.370-375, April.2013.
[19] Paliwal, “ Pharmacognostic parameters for evaluation of the rhizomes of Curcuma caesia”, J. Adv. Pharm. Tech. Res., 2: 56 -61.2007.
[20] A. Wang, Y. Cui, J. Li, J.C.M.and van Hest, “Fabrication of gelatin micro gels by a cast strategy for controlled drug release” Adv. Funct. Mater. 22 ,pp.2673–2681.2012.
[21] Heisanam Pushparani Devi, P.B. Mazumder,⁎ and Laishram Priyadarshini Devi,” Antioxidant and antimutagenic activity of Curcuma caesia Roxb. rhizome extracts”, Toxicol Rep. 2: 423–428.2015